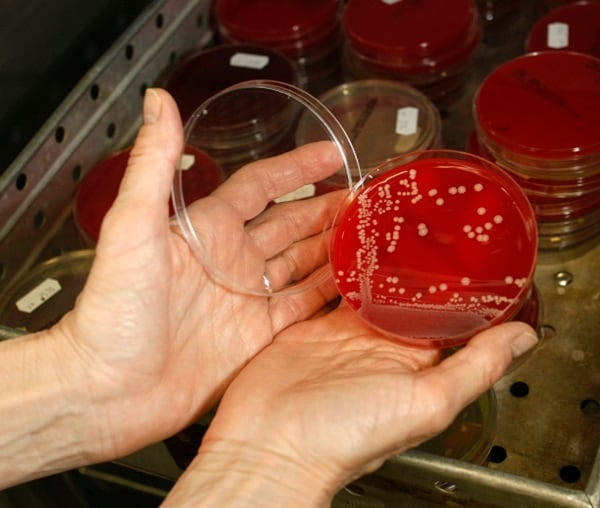

Жидкие питательные среды в микробиологии

.jpg)




















Раздел: Галерея прозрений